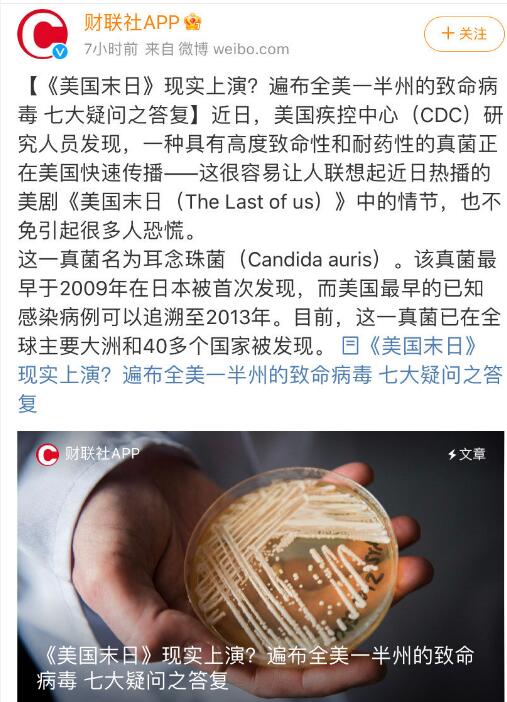

耳念珠菌通过血液、伤口、耳部感染,免疫系统正常的人可携带而不感染
发布时间:2023-03-23 14:12:26 来源:未知 编 辑:9W编辑✔
|
耳念珠菌在美国蔓延,近半感染者90天内死亡!常用消毒剂无效,目前已遍布美国一半以上的州,成为紧迫的公共卫生威胁。
![]() 这种真菌的厉害之处?就是如果存在耐药性,感染之后,绝大多数的抗真菌药都没有作用。耳念珠菌既往一般是散发感染,只感染少数复杂的重病人。
真菌感染对重症病人非常危险,特别是真菌进入患者的血液、心脏和大脑时,往往是致命的。
念珠菌导致的症状取决于感染的位置,包括血流感染、伤口感染和耳部感染等;其中血流感染最为严重,病死率可达30-40%。如免疫抑制状态、严重的医学合并症、近期做过手术、肠外营养、长期使用广谱抗菌药物及抗真菌药、重症监护室住院时间长、侵入性操作等等。
免疫力正常的人可携带这种超级真菌而不引起感染,但可传播给他人。
普通人的预防重点是做好手卫生和皮肤的卫生,特别是双侧腋窝和腹股沟等部位要注意清洗和消毒,避免接触高危人群。
|